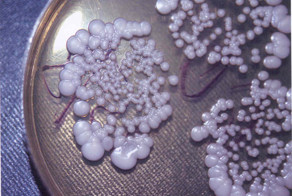
Рак излечим, просто это кому-то не выгодно

649
2
К нам в лапы недавно попал ребенок. Подросток. Большая семья, 2 младших братика. Мама - антипрививочница. Ребенка несмотря на отсутствие справки от фтизиатра - взяли в школу. А она (ребенок) все что то болеет. Подкашливает. Наконец мама согласилась сделать снимок...
Результат - инфильтративный туберкулез с распадом. Контактные - сотни детей. СОТНИ - принимают профилактические препараты. СОТНЯМ делаем КТ или диаскинтест - ищем туберкулез, ищем латентную инфекцию.
Школу штрафуют на несколько сотен тысяч. Директора на 70 тыс. А девочка будет лечиться, гдето месяцев 10, а может и год, как пойдет. Пятью препаратами, уколы, капельницы, Потом реабилитация. Мы ее вылечим. Но год жизни она проведет в больничке. Из-за невежды матери. Из-за того что мы ее не убедили что нам можно довериться... Слава Богу мать одумалась. Сейчас лечим и дочку и превентивно всю семью и пол школы. Я не пугаю вас - это жизнь! Берегите детей и не болейте!
В Москве ситуация с туберкулезом - очень хорошая. Потому что мы работаем. Не надо нам мешать! Мы заботимся и защищаем Ваших детей! Не бойтесь наших манипуляций - они безвредны - но они работают.
Автор: Григорий Климов, Московский научно-практический центр борьбы с туберкулёзом
Школу штрафуют на несколько сотен тысяч. Директора на 70 тыс. А девочка будет лечиться, гдето месяцев 10, а может и год, как пойдет. Пятью препаратами, уколы, капельницы, Потом реабилитация. Мы ее вылечим. Но год жизни она проведет в больничке. Из-за невежды матери. Из-за того что мы ее не убедили что нам можно довериться... Слава Богу мать одумалась. Сейчас лечим и дочку и превентивно всю семью и пол школы. Я не пугаю вас - это жизнь! Берегите детей и не болейте!
В Москве ситуация с туберкулезом - очень хорошая. Потому что мы работаем. Не надо нам мешать! Мы заботимся и защищаем Ваших детей! Не бойтесь наших манипуляций - они безвредны - но они работают.
Автор: Григорий Климов, Московский научно-практический центр борьбы с туберкулёзом
Источник: Facebook (запрещён в РФ)
Ссылки по теме:
- Изуродованную девочку выгнали из закусочной
- Рак излечим, просто это кому-то не выгодно
- Президент Чили навестила больную девочку, попросившую ее об эвтаназии
- Мартовский учебник
- Трагедия на дороге
реклама

с прививками совсем другая история
Мнение иммунолога, и в прошлом вирусолога.
В отличие от Вас.